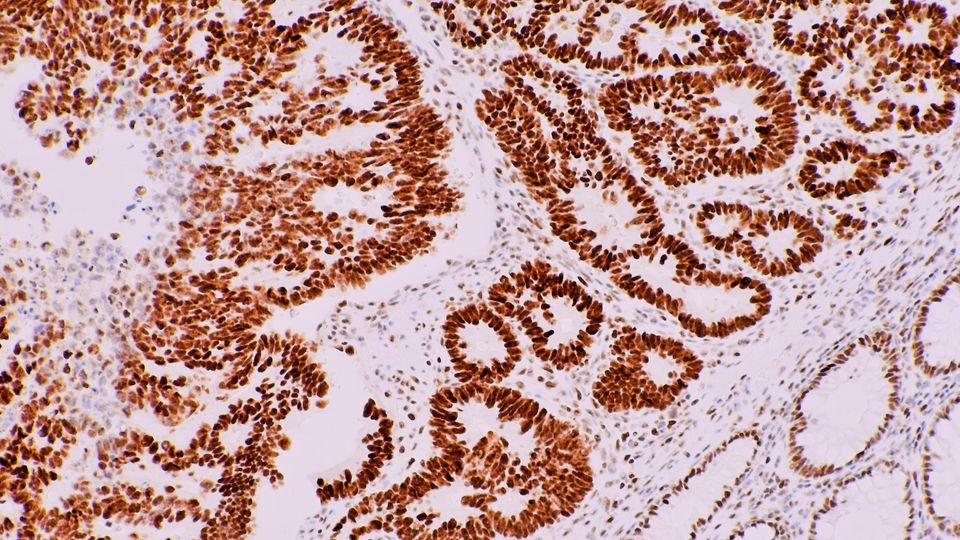

Work Experiences

Software Developer
PeblHealth (March 2024 – Present)
At Pebl Health, I contribute to the development of scalable, data-driven digital health solutions by building end-to-end features across the product stack. My work spans front-end and back-end development, including designing user-centric interfaces, optimizing API integrations, and implementing robust data pipelines that support real-time analytics. I collaborate with product, engineering, and clinical teams to translate complex requirements into clean, maintainable code and high-impact features.
I work with modern frameworks, cloud-based infrastructure, and agile development workflows—including version control (Git), CI/CD pipelines, RESTful API architecture, database optimization, and modular code design. I regularly perform debugging, refactoring, and performance tuning to ensure system reliability, scalability, and seamless user experience. My role also involves writing technical documentation, contributing to architecture discussions, and supporting long-term product roadmap planning. Through this work, I’ve strengthened my expertise in software engineering best practices, problem-solving, and building high-quality digital products in a fast-paced, mission-driven environment.
Occupational Therapy
The Educational Resource Group (November 2024 – Current)
At the Educational Resource Group, I work as an occupational therapy coach, supporting students in developing the functional, cognitive, and motor skills they need to succeed both in and out of the classroom. I design and lead individualized, goal-focused sessions that target fine motor development, handwriting improvement, sensory integration, visual-motor coordination, executive functioning, and self-regulation skills. My work involves assessing student needs, creating tailored interventions, and adapting activities to meet each learner where they are.
I collaborate closely with certified OTs, teachers, and families to ensure consistency across home, school, and therapy environments, while documenting progress and adjusting plans as students grow. I also help implement sensory strategies, classroom accommodations, and task-modification techniques that improve focus, confidence, and independence. This role has strengthened my leadership, communication, and problem-solving skills and has given me deeper insight into child development, therapeutic methodology, and holistic approaches to supporting students.


Piano Instructor
Private Studio (February 2021 – Present)
I teach beginner and intermediate students the fundamentals of piano performance, music theory, and expressive playing. I design personalized lesson plans that build strong technique, rhythm, sight-reading skills, and musical confidence, adapting my teaching style to each student’s age, goals, and learning pace. My approach blends structured curriculum with creative exploration, helping students develop a solid foundation in scales, chords, ear training, and repertoire while fostering a genuine enjoyment of music.
I work with students to prepare for recitals, school performances, and personal goals, providing clear practice strategies and constructive feedback that support consistent progress. Through one-on-one coaching, I emphasize discipline, patience, and self-expression—creating an encouraging environment where students can grow not only as musicians but also in focus, perseverance, and creativity.
Neuroscience Research
Johns Hopkins University (July 2022 – July 2024)
During my time at Johns Hopkins, I contributed to behavioral and systems neuroscience research focused on understanding how the visual cortex processes information during decision-making tasks. I engineered and optimized custom behavioral apparatuses using Arduino, Raspberry Pi, and various sensors, ensuring precise stimulus delivery and reliable data capture. I routinely prepared high-quality histological brain sections, performed immunohistochemistry to label specific neural markers, and maintained organized experimental logs for reproducibility.
I assisted in running head-fixed mouse behavioral experiments, monitoring trial performance, calibrating equipment, and troubleshooting hardware and software issues in real time. My work also involved data organization, quality control, and contributing to protocol improvements to enhance experimental efficiency. This role strengthened my technical skill set, attention to detail, and ability to work independently in a research-intensive environment, while giving me a deeper understanding of neuroscience methodologies—including experimental design, electrophysiology principles, and animal behavior analysis.
My Plans
Looking ahead, I want to continue diving deeper into neuroscience—understanding the brain not just as a system, but as a story of patterns, decisions, behavior, and everything that makes us human. My goal is to build a career where research, technology, and creativity intersect. I plan to gain as much hands-on experience as I can, whether that’s through data entry, data analysis, research internships, or any opportunity that helps me grow my technical and scientific toolkit.
I want to work in labs, build projects, collaborate with people smarter than me, and keep expanding the way I see the world. Every skill I pick up—coding, analysis, design, or research—is something I want to fold into a larger vision of becoming a well-rounded neuroscientist who isn’t afraid to experiment, learn, and adapt.
Eventually, I want to contribute to research that feels meaningful, help push discoveries forward, and build a future where I’m constantly improving both myself and the spaces I work in.
And if everything goes according to plan? Great. If not… I’ll simply rebrand and try again.